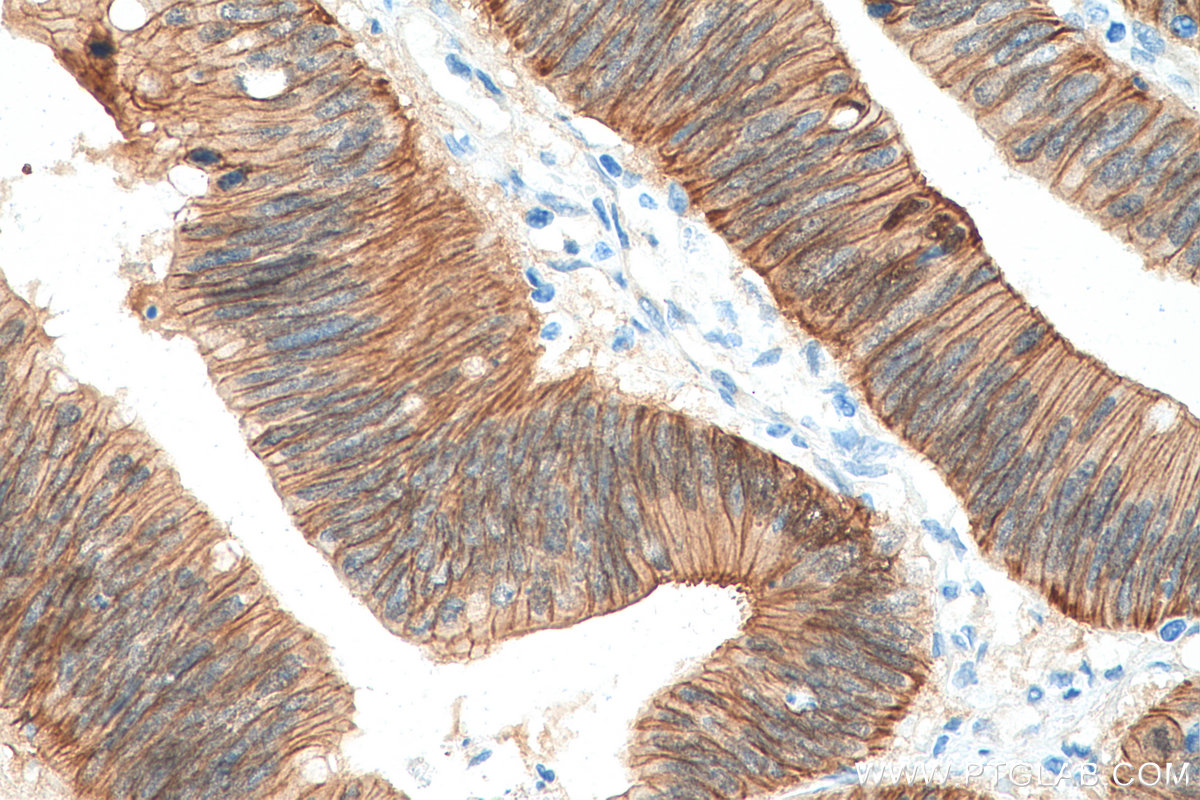

验证数据展示
经过测试的应用
| Positive WB detected in | A431 cells, zebrafish tissue, HeLa cells, HEK-293 cells, MCF-7 cells, LNCaP cells, HSC-T6 cells, NIH/3T3 cells, 4T1 cells, pig brain tissue |
| Positive IHC detected in | human liver cancer tissue, human breast cancer tissue, human colon cancer tissue, human rectal cancer tissue Note: suggested antigen retrieval with TE buffer pH 9.0; (*) Alternatively, antigen retrieval may be performed with citrate buffer pH 6.0 |
| Positive IF-P detected in | mouse colon tissue, rat pancreas tissue |
| Positive IF/ICC detected in | MCF-7 cells |
| Positive ChIP-qPCR detected in | HCT 116 cells |
推荐稀释比
| 应用 | 推荐稀释比 |
|---|---|
| Western Blot (WB) | WB : 1:5000-1:50000 |
| Immunohistochemistry (IHC) | IHC : 1:1000-1:4000 |
| Immunofluorescence (IF)-P | IF-P : 1:200-1:800 |
| Immunofluorescence (IF)/ICC | IF/ICC : 1:1000-1:4000 |
| CHIP-QPCR | CHIP-QPCR : 1:10-1:100 |
| It is recommended that this reagent should be titrated in each testing system to obtain optimal results. | |
| Sample-dependent, Check data in validation data gallery. | |
产品信息
80488-1-RR targets Beta Catenin in WB, IHC, IF/ICC, IF-P, CoIP, ELISA, ChIP-qPCR applications and shows reactivity with human, mouse, rat, pig, zebrafish samples.
| 经测试应用 | WB, IHC, IF/ICC, IF-P, ELISA, ChIP-qPCR Application Description |
| 文献引用应用 | WB, IF, CoIP, ChIP |
| 经测试反应性 | human, mouse, rat, pig, zebrafish |
| 文献引用反应性 | human, mouse |
| 免疫原 |
Peptide 种属同源性预测 |
| 宿主/亚型 | Rabbit / IgG |
| 抗体类别 | Recombinant |
| 产品类型 | Antibody |
| 全称 | catenin (cadherin-associated protein), beta 1, 88kDa |
| 别名 | b cat, B-catenin, beta-Catenin, Catenin beta 1, Catenin beta-1 |
| 计算分子量 | 781 aa, 86 kDa |
| 观测分子量 | 92 kDa |
| GenBank蛋白编号 | BC058926 |
| 基因名称 | Beta Catenin |
| Gene ID (NCBI) | 1499 |
| ENSEMBL Gene ID | ENSG00000168036 |
| RRID | AB_2918895 |
| 偶联类型 | Unconjugated |
| 形式 | Liquid |
| 纯化方式 | Protein A purification |
| UNIPROT ID | P35222 |
| 储存缓冲液 | PBS with 0.02% sodium azide and 50% glycerol, pH 7.3. |
| 储存条件 | Store at -20°C. Stable for one year after shipment. Aliquoting is unnecessary for -20oC storage. |
背景介绍
β-Catenin, also known as CTNNB1, is an evolutionarily conserved, multifunctional intracellular protein. β-Catenin is a 92-kDa protein, originally identified in cell adherens junctions (AJs) where it functions to bridge the cytoplasmic domain of cadherins to a-catenin and the actin cytoskeleton. Besides its essential role in the AJs, β-catenin is also a key downstream component of the canonical Wnt pathway that plays diverse and critical roles in embryonic development and adult tissue homeostasis. The Wnt/β-catenin pathway is also involved in the activation of other intracellular messengers such as calcium fluxes, JNK, and SRC kinases. Deregulation of β-catenin activity is associated with multiple diseases including cancers. (PMID: 22617422; 18334222)
实验方案
| Product Specific Protocols | |
|---|---|
| IF protocol for Beta Catenin antibody 80488-1-RR | Download protocol |
| IHC protocol for Beta Catenin antibody 80488-1-RR | Download protocol |
| WB protocol for Beta Catenin antibody 80488-1-RR | Download protocol |
| Standard Protocols | |
|---|---|
| Click here to view our Standard Protocols |
发表文章
| Species | Application | Title |
|---|---|---|
Cell Biol Toxicol M6A modification-mediated LIMA1 promotes the progression of hepatocellular carcinoma through the wnt-βcatenin/Hippo pathway | ||
Discov Oncol miR-124-3p inhibits CRC proliferation, migration, and invasion by targeting ITGB1 | ||
J Pharmacol Exp Ther Alleviation of metabolic dysfunction-associated steatotic liver disease by silymarin is associated with maintaining mitochondrial homeostasis via regulation of optic atrophy 1. | ||
Front Cell Infect Microbiol Brucella melitensis clinical isolate modulates osteoclast differentiation to drive pathological bone destruction in brucellar arthritis. |